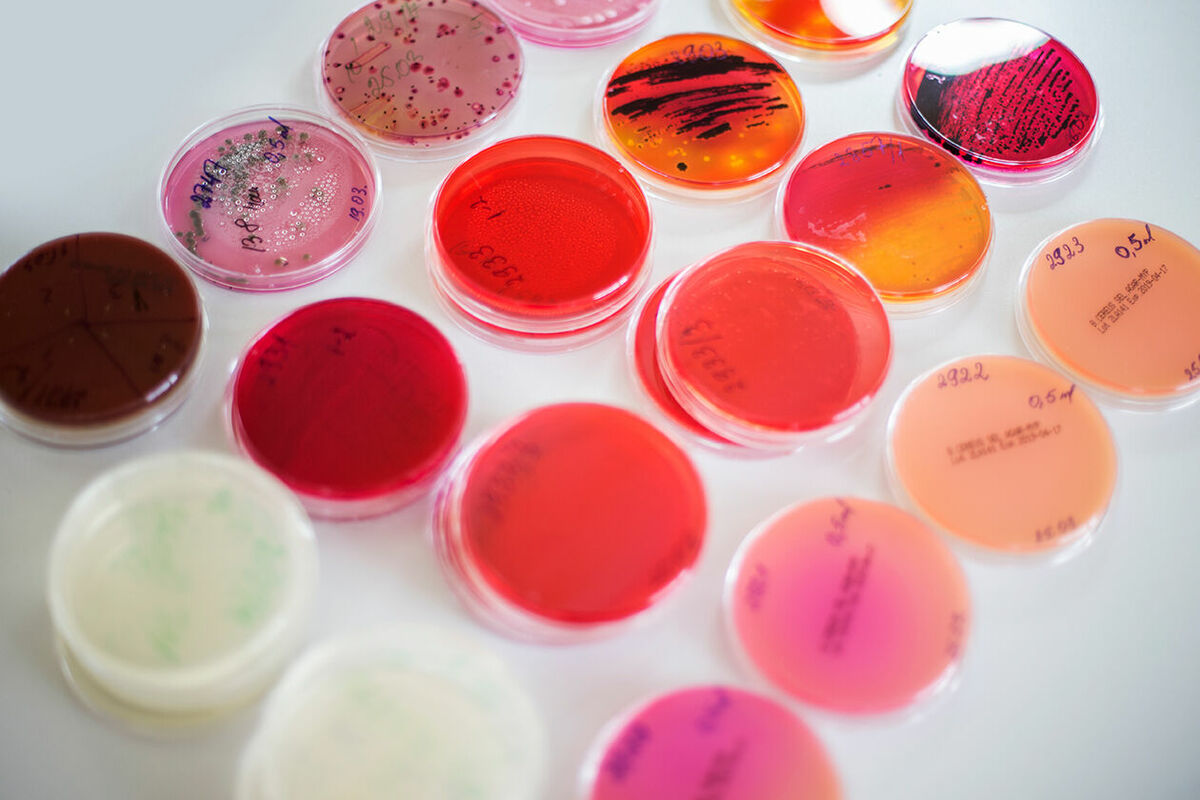

"Laboratorija AUCTORITAS" 0
Rūpniecības iela 4, Alūksne, Alūksnes nov., LV-4301
 Akreditēta laboratorija
Akreditēta laboratorija
 Pārtikas produktu analīzes
Pārtikas produktu analīzes
 ūdens analīzes
ūdens analīzes
 peldbaseinu analīzes
peldbaseinu analīzes
 dzeramā ūdens analīzes
dzeramā ūdens analīzes
 Gaisa analīzes
Gaisa analīzes
 Gaisa analīzes
Gaisa analīzes
 Dzeramā ūdens
Dzeramā ūdens
 peldbaseinu ūdens mikrobioloģiskās analīzes
peldbaseinu ūdens mikrobioloģiskās analīzes
Paraugu ņemšana
Paraugu ņemšana
 Gaisa analīzes
Gaisa analīzes
 Laboratoriskie izmeklējumi
Laboratoriskie izmeklējumi
 Gaisa analīzes
Gaisa analīzes
 Virsmu nomazgājumu mikrobioloģiskās analīzes
Virsmu nomazgājumu mikrobioloģiskās analīzes
 Kosmētikas testēšana
Kosmētikas testēšana
 Dzeramā ūdens monitorings
Dzeramā ūdens monitorings
